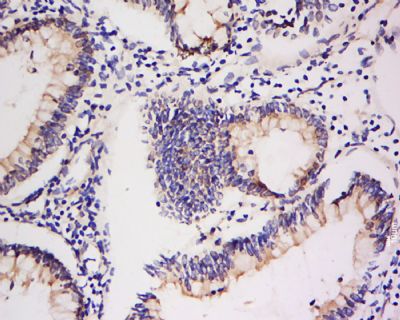
产品细节图片2

相关产品推荐更多 >
万千商家帮你免费找货
0 人在求购买到急需产品
- 详细信息
- 文献和实验
- 技术资料
- 供应商:
上海康朗生物科技有限公司
- 库存:
大量
- 目录编号:
kl-1356R
- 克隆性:
多克隆
- 抗原来源:
Rabbit
- 保质期:
12个月
- 抗体英文名:
Integrin Alpha V + Beta 5 antibody
- 抗体名:
整合素αVβ5抗体
- 宿主:
Rabbit
- 适应物种:
Human, Mouse, Rat,
- 免疫原:
KLH conjugated synthetic peptide derived from human Integrin beta 5 and Integrin alpha V C-terminus:
- 亚型:
IgG
- 形态:
冻干粉或液体
- 应用范围:
ELISA=1:500-1000 IHC-P=1:400-800 IHC-F=1:400-800 Flow-Cyt=1μg/Test IF=1:100-500
- 浓度:
1mg/ml
- 保存条件:
-20 °C
- 规格:
50ul 100ul 200ul
| 中文名称 | 整合素αVβ5抗体 |
| 别 名 | alpha 5; alpha polypeptide; CD49e; CD51; fibronectin receptor; FNRA; Integrin alpha V; Integrin beta 5; ITGA5; ITGAV; ITGB5; VLA5A; VNRA. |
![]() |
Specific References (3) | bs-1356R has been referenced in 3 publications. [IF=7.60] Mondal, Goutam, Sugata Barui, and Arabinda Chaudhuri. "The relationship between the cyclic-RGDfK ligand and ??v??3 integrin receptor."iomaterials (2013).ii Human. PubMed:23702147 [IF=2.47] Chen, Ming, et al. "Periostin activates pathways involved in epithelial-mesenchymal transition in adamantinomatous craniopharyngioma." Journal of the Neurological Sciences (2015). WB ; Human. PubMed:26723972 [IF=3.55] Bian, Qin, et al. "Mechanosignaling activation of TGFβ maintains intervertebral disc homeostasis." Bone Research 5 (2017): 17008. IHC-P ; Mouse. PubMed:28392965 |
| 规格价格 | 50ul/780元 购买 100ul/1380元 购买 200ul/2200元 购买 大包装/询价 |
| 说 明 书 | 50ul 100ul 200ul |
| 研究领域 | 细胞生物 干细胞 细胞粘附分子 |
| 抗体来源 | Rabbit |
| 克隆类型 | Polyclonal |
| 交叉反应 | Human, Mouse, Rat, |
| 产品应用 | ELISA=1:500-1000 IHC-P=1:400-800 IHC-F=1:400-800 Flow-Cyt=1μg/Test IF=1:100-500 (石蜡切片需做抗原修复) not yet tested in other applications. optimal dilutions/concentrations should be determined by the end user. |
| 分 子 量 | 88/121kDa |
| 细胞定位 | 细胞膜 |
| 性 状 | Lyophilized or Liquid |
| 浓 度 | 1mg/ml |
| 免 疫 原 | KLH conjugated synthetic peptide derived from human Integrin beta 5 and Integrin alpha V C-terminus: |
| 亚 型 | IgG |
| 纯化方法 | affinity purified by Protein A |
| 储 存 液 | 0.01M TBS(pH7.4) with 1% BSA, 0.03% Proclin300 and 50% Glycerol. |
| 保存条件 | Store at -20 °C for one year. Avoid repeated freeze/thaw cycles. The lyophilized antibody is stable at room temperature for at least one month and for greater than a year when kept at -20°C. When reconstituted in sterile pH 7.4 0.01M PBS or diluent of antibody the antibody is stable for at least two weeks at 2-4 °C. |
| PubMed | PubMed |
| 产品介绍 | background: Integrins are heterodimeric proteins made up of alpha and beta subunits. At least 18 alpha and 8 beta subunits have been described in mammals. Integrin family members are membrane receptors involved in cell adhesion and recognition in a variety of processes including embryogenesis, hemostasis, tissue repair, immune response and metatastatic diffusion of tumour cells. ITAGV encodes integrin alpha chain V. Integrins are heterodimeric integral membrane proteins composed of an alpha chain and a beta chain. The I-domain containing integrin alpha V undergoes post-translational cleavage to yield disulfide-linked heavy and light chains, that combine with multiple integrin beta chains to form different integrins. Among the known associating beta chains (beta chains 1,3,5,6, and 8; ITGB1, ITGB3, ITGB5, ITGB6, and ITGB8), each can interact with extracellular matrix ligands; the alpha V beta 3 integrin, perhaps the most studied of these, is referred to as the Vitronectin receptor (VNR). In addition to adhesion, many integrins are known to facilitate signal transduction. Subcellular Location: Cell Membrane SWISS: P06756 Gene ID: 3685 Database links: Entrez Gene: 395142 Chicken Entrez Gene: 396420 Chicken Entrez Gene: 3685 Human Entrez Gene: 3693 Human Omim: 147561 Human Omim: 193210 Human SwissProt: P26008 Chicken SwissProt: P06756 Human SwissProt: P18084 Human Unigene: 436873 Human Unigene: 536663 Human Important Note: This product as supplied is intended for research use only, not for use in human, therapeutic or diagnostic applications. 整合素αVβ3、αVβ5是特异性表达在血管内皮细胞表面的粘附因子,在介导内皮细胞和ECM相互接触中起作用。 整合素(integrin)分布广泛,属于细胞黏附分子家族。经研究发现整合素可以调节细胞-细胞、细胞-细胞外基质(extracellular matrix,ECM〕间的黏附。整合素所介导的肿瘤细胞与ECM间的相互作用影响肿瘤的发生、增殖、侵袭和转移到其他组织的能力。 |
| 产品图片 | ![]() Tissue/cell: Human colon cancer; 4% Paraformaldehyde-fixed and paraffin-embedded; Antigen retrieval: citrate buffer ( 0.01M, pH 6.0 ), Boiling bathing for 15min; Block endogenous peroxidase by 3% Hydrogen peroxide for 30min; Blocking buffer (normal goat serum,C-0005) at 37℃ for 20 min; Incubation: Anti-Integrin Alpha V + Beta 5 Polyclonal Antibody, Unconjugated(bs-1356R) 1:200, overnight at 4°C, followed by conjugation to the secondary antibody(SP-0023) and DAB(C-0010) staining ![]() Cell: A549 Concentration:1:100 Host/Isotype:Rabbit/IgG Flow cytometric analysis of Rabbit IgG isotype control (Cat#: bs-1356R) on A549(green) compared with control in the absence of primary antibody (blue) followed by Alexa Fluor 488-conjugated goat anti-rabbit IgG(H+L) secondary antibody . |
风险提示:丁香通仅作为第三方平台,为商家信息发布提供平台空间。用户咨询产品时请注意保护个人信息及财产安全,合理判断,谨慎选购商品,商家和用户对交易行为负责。对于医疗器械类产品,请先查证核实企业经营资质和医疗器械产品注册证情况。
文献和实验v468. chapter 4 WNT 细胞通路 检测细胞GSK3活性与表达水平
consists of 5% (w/v) dried skim milk in Trisbufferedsaline/Tween-20 (TBS-T) buffer (50 mM Tris-HCl,pH 7.5, 150 mM NaCl, and 0.05% (v/v) Tween-20). 4. All antibodies are diluted 1:1,000 in 1% (w/v) dried skim milkin TBS-T, except the CRMP2 antibody (1:250
V294.PART II,Chapter 5 细胞粘附实验(英文版)
, C., Chung, A. E., and McDonald, J. A. (1995) A novel role for alpha 3 beta 1integrins in extracellular matrix assembly. J. Cell Sci. 108, 2511–2523. 9. Lotz, M. M., Burdsal, C. A., Erickson, H. P., and McClay, D. R. (1989) Celladhesion
β亚单位,除α7和αIEL外,其它粘合素分子亚单位均已基因克隆成功。α亚单位和β亚单位组合构成粘合素分子并不是随机的,多数α亚单位只能与一种β亚单位结合构成异源双体,但也有的α亚单位可与几种不同的β亚单位组合,如αV(CD51)可分别同β1、β3、β5、β6和β8亚单位组成integrin分子,而大部分β单位则可以结合数种不同
技术资料暂无技术资料 索取技术资料